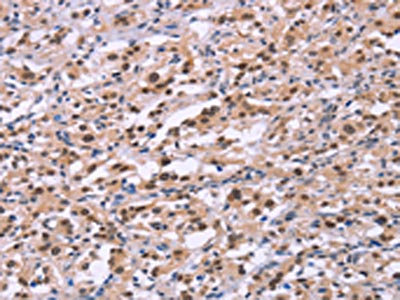

EP300 Antibody
-
中文名稱:EP300兔多克隆抗體
-
貨號:CSB-PA715796
-
規格:¥1100
-
圖片:
-
The image on the left is immunohistochemistry of paraffin-embedded Human gastic cancer tissue using CSB-PA715796(EP300 Antibody) at dilution 1/20, on the right is treated with synthetic peptide. (Original magnification: ×200)
-
The image on the left is immunohistochemistry of paraffin-embedded Human thyroid cancer tissue using CSB-PA715796(EP300 Antibody) at dilution 1/20, on the right is treated with synthetic peptide. (Original magnification: ×200)
-
-
其他:
產品詳情
-
Uniprot No.:
-
基因名:
-
別名:E1A associated protein p300 antibody; E1A binding protein p300 antibody; E1A-associated protein p300 antibody; EP300 antibody; EP300: E1A binding protein p300 antibody; EP300_HUMAN antibody; Histone acetyltransferase p300 antibody; KAT3B antibody; p300 HAT antibody; RSTS2 antibody
-
宿主:Rabbit
-
反應種屬:Human,Mouse
-
免疫原:Synthetic peptide of Human EP300
-
免疫原種屬:Homo sapiens (Human)
-
標記方式:Non-conjugated
-
抗體亞型:IgG
-
純化方式:Antigen affinity purification
-
濃度:It differs from different batches. Please contact us to confirm it.
-
保存緩沖液:-20°C, pH7.4 PBS, 0.05% NaN3, 40% Glycerol
-
產品提供形式:Liquid
-
應用范圍:ELISA,IHC
-
推薦稀釋比:
Application Recommended Dilution ELISA 1:1000-1:2000 IHC 1:25-1:100 -
Protocols:
-
儲存條件:Upon receipt, store at -20°C or -80°C. Avoid repeated freeze.
-
貨期:Basically, we can dispatch the products out in 1-3 working days after receiving your orders. Delivery time maybe differs from different purchasing way or location, please kindly consult your local distributors for specific delivery time.
-
用途:For Research Use Only. Not for use in diagnostic or therapeutic procedures.
相關產品
靶點詳情
-
功能:Functions as histone acetyltransferase and regulates transcription via chromatin remodeling. Acetylates all four core histones in nucleosomes. Histone acetylation gives an epigenetic tag for transcriptional activation. Mediates cAMP-gene regulation by binding specifically to phosphorylated CREB protein. Mediates acetylation of histone H3 at 'Lys-122' (H3K122ac), a modification that localizes at the surface of the histone octamer and stimulates transcription, possibly by promoting nucleosome instability. Mediates acetylation of histone H3 at 'Lys-27' (H3K27ac). Also functions as acetyltransferase for non-histone targets, such as ALX1, HDAC1, PRMT1 or SIRT2. Acetylates 'Lys-131' of ALX1 and acts as its coactivator. Acetylates SIRT2 and is proposed to indirectly increase the transcriptional activity of TP53 through acetylation and subsequent attenuation of SIRT2 deacetylase function. Acetylates HDAC1 leading to its inactivation and modulation of transcription. Acetylates 'Lys-247' of EGR2. Acts as a TFAP2A-mediated transcriptional coactivator in presence of CITED2. Plays a role as a coactivator of NEUROD1-dependent transcription of the secretin and p21 genes and controls terminal differentiation of cells in the intestinal epithelium. Promotes cardiac myocyte enlargement. Can also mediate transcriptional repression. Acetylates FOXO1 and enhances its transcriptional activity. Acetylates BCL6 wich disrupts its ability to recruit histone deacetylases and hinders its transcriptional repressor activity. Participates in CLOCK or NPAS2-regulated rhythmic gene transcription; exhibits a circadian association with CLOCK or NPAS2, correlating with increase in PER1/2 mRNA and histone H3 acetylation on the PER1/2 promoter. Acetylates MTA1 at 'Lys-626' which is essential for its transcriptional coactivator activity. Acetylates XBP1 isoform 2; acetylation increases protein stability of XBP1 isoform 2 and enhances its transcriptional activity. Acetylates PCNA; acetylation promotes removal of chromatin-bound PCNA and its degradation during nucleotide excision repair (NER). Acetylates MEF2D. Acetylates and stabilizes ZBTB7B protein by antagonizing ubiquitin conjugation and degragation, this mechanism may be involved in CD4/CD8 lineage differentiation. Acetylates GABPB1, impairing GABPB1 heterotetramerization and activity. In addition to protein acetyltransferase, can use different acyl-CoA substrates, such as (2E)-butenoyl-CoA (crotonyl-CoA), butanoyl-CoA (butyryl-CoA), 2-hydroxyisobutanoyl-CoA (2-hydroxyisobutyryl-CoA), lactoyl-CoA or propanoyl-CoA (propionyl-CoA), and is able to mediate protein crotonylation, butyrylation, 2-hydroxyisobutyrylation, lactylation or propionylation, respectively. Acts as a histone crotonyltransferase; crotonylation marks active promoters and enhancers and confers resistance to transcriptional repressors. Histone crotonyltransferase activity is dependent on the concentration of (2E)-butenoyl-CoA (crotonyl-CoA) substrate and such activity is weak when (2E)-butenoyl-CoA (crotonyl-CoA) concentration is low. Also acts as a histone butyryltransferase; butyrylation marks active promoters. Catalyzes histone lactylation in macrophages by using lactoyl-CoA directly derived from endogenous or exogenous lactate, leading to stimulates gene transcription. Acts as a protein-lysine 2-hydroxyisobutyryltransferase; regulates glycolysis by mediating 2-hydroxyisobutyrylation of glycolytic enzymes. Functions as a transcriptional coactivator for SMAD4 in the TGF-beta signaling pathway. Acetylates PCK1 and promotes PCK1 anaplerotic activity. Acetylates RXRA and RXRG.; (Microbial infection) In case of HIV-1 infection, it is recruited by the viral protein Tat. Regulates Tat's transactivating activity and may help inducing chromatin remodeling of proviral genes. Binds to and may be involved in the transforming capacity of the adenovirus E1A protein.
-
基因功能參考文獻:
- Systems approach revealed that histone deacetylation is strongly associated with the suppression of EP300 target genes implicated in diabetes. PMID: 28886276
- novel EP300 mutations were found in Rubinstein-Taybi 2 syndrome PMID: 29506490
- p300 autoacetylation is associated with tongue neoplasms. PMID: 29746960
- Results show that p300 recruitment along with binding to histones are required for cMyb to fully activate transcription of a chromatinembedded gene. PMID: 29954426
- Our data show that the hyperacetylation of Tau by p300 histone acetyltransferase (HAT) disfavors liquid-liquid phase separation , inhibits heparin-induced aggregation, and impedes access to LLPS-initiated microtubule assembly PMID: 29734651
- EP300 variants are associated with Rubinstein-Taybi syndrome. PMID: 29133209
- High P300 expression is associated with recurrence in prostate cancer. PMID: 29262808
- Data generated with primary human hepatic stellate cells (HSC) supports that stiffness-mediated HSC activation requires p300. PMID: 29454793
- The histone acylation activity of p300 can be activated by pre-existing lysine crotonylation through a positive feedback mechanism. PMID: 29584949
- epigenomic profiling of clear cell renal cell carcinoma (ccRCC) establishes a compendium of somatically altered cis-regulatory elements, uncovering new potential targets including ZNF395. Loss of VHL, a ccRCC signature event, causes pervasive enhancer malfunction, with binding of enhancer-centric HIF2a and recruitment of histone acetyltransferase p300 at preexisting lineage-specific promoter-enhancer complexes PMID: 28893800
- Histone acetyltransferase EP300 is necessary for the transcription factor SOX2 activity in basal cells, including for induction of the squamous fate. EP300 copy number gains are common in squamous cell carcinoma SQCCs, including lung cancer SQCC cell lines. PMID: 28794006
- High expression of EP300 is associated with colorectal cancer. PMID: 28586030
- Transcriptional coactivator p300 gene polymorphism correlates with the development and advancement of diabetic kidney disease. Additionally, the SIRT1 gene collaborates with the p300 gene and participates in promoting albuminuria in type 2 diabetes mellitus patients. PMID: 28444663
- These results suggest that EP300 harbors adaptive variants in Tibetans, which might contribute to high-altitude adaptation through regulating NO production. PMID: 28585440
- EP300 plays a major role in the reprogramming events, leading to a more malignant phenotype with the acquisition of drug resistance and cell plasticity, a characteristic of metaplastic breast cancer. PMID: 28341962
- E-cadherin expression was increased by transfection of p300 small interfering RNA in a dose-dependent manner.. There was a correlation between Snail and p300 expressions in lung cancer. Moreover, p300 acetylates Snail both in vivo and in vitro, and K187 may be involved in this modification. PMID: 28296173
- Two possible modes of pioneering associated with combinations of H2A.Z and p300/CBP at nucleosome-occupied enhancers. PMID: 28301306
- these results demonstrate that the reversible acetylation of FOXM1 by p300/CBP and SIRT1 modulates its transactivation function PMID: 27542221
- p300 inhibition attenuates both thrombin induced-CCL2 expression and histone H3 and H4 acetylation in HLFs, suggesting that p300 is involved in thrombin-induced CCL2 expression via hyperacetylating histone H3 and H4. PMID: 28407300
- p300-dependent histone H3 acetylation and C/EBPbeta-regulated IKKbeta expression contribute to thrombin-induced IL-8/CXCL8 expression in human lung epithelial cells. PMID: 28428115
- High p300 expression is associated with prostate cancer growth. PMID: 26934656
- CREBBP and EP300 mutations remained significant to predict worse OS, PFS, and EFS. PMID: 28302137
- Data indicate that acetyltransferase p300 acetylates oncogenic E3 ubiquitin ligase murine double minute 2 (MDM2) at Lys182 and Lys185. PMID: 28196907
- results demonstrated that XRCC5 promoted colon cancer growth by cooperating with p300 to regulate COX-2 expression, and suggested that the XRCC5/p300/COX-2 signaling pathway was a potential target in the treatment of colon cancers PMID: 29049411
- EP300-ZNF384 mediates GATA3 gene expression and may be involved in the acquisition of the HSC gene expression signature and characteristic immunophenotype in B-cell precursor acute lymphoblastic leukemia cells. PMID: 28378055
- Estrogen receptor recruits steroid receptor coactivator-3 primary coactivator and secondary coactivators, p300/CBP and CARM1 to regulate genetic transcription. PMID: 28844863
- the depleted beta-Arrestin1 reduced the interaction of P300 with Sp1, thus to reduce Sp1 binding to hTERT promoter, downregulate hTERT transcription, decrease telomerase activity, shorten telomere length, and promote Reh cell senescence. PMID: 28425985
- Authors report that p300 and CBP acetylate Mastermind-like 1 (Maml1) on amino acid residues K188 and K189 to recruit NACK to the Notch1 ternary complex, which results in the recruitment of RNA polymerase II to initiate transcription. PMID: 28625977
- Genome-wide gene expression profiling identified a network of VEGF-responsive and ERG-dependent genes. PMID: 28536097
- our findings identify the TXN-FOXO1-p300 circuit as the sensor and effector of oxidative stress in DLBCL cells PMID: 27132507
- Acetylation-dependent control of global poly(A) RNA degradation by CBP/p300 and HDAC1-HDAC2 has been described. PMID: 27635759
- Although TP53 and BAX immunoreactivity levels were associated with some clinicopathological parameters of the patients, the expression of EP300, TP53 and BAX did not reveal any prognostic significance in ccRCC PMID: 28551630
- CTPB promoted the survival and neurite growth of the SH-SY5Y cells, and also protected these cells from cell death induced by the neurotoxin 6-hydroxydopamine. This study is the first to investigate the phenotypic effects of the HAT activator CTPB, and to demonstrate that p300/CBP HAT activation has neurotrophic effects in a cellular model of Parkinson's Disease. PMID: 27256286
- c-Jun and p300 are novel interacting partners of AEG-1 in gliomas. PMID: 27956703
- 2-O, 3-O desulfated heparin inhibited HMGB1 release, at least in part, by direct molecular inhibition of p300 HAT activity. PMID: 27585400
- A potential mechanism for the role of Sirt1 in lung fibrosis was through regulating the expression of p300. Thus, we characterized Sirt1 as an important regulator of lung fibrosis and provides a proof of principle for activation or overexpression of Sirt1 as a potential novel therapeutic strategy for IPF. PMID: 28365154
- Results suggest that increase in nuclear expression of p300, as well as the presence of cytoplasmic but loss of nuclear expression of p300/CBP-associated factor (PCAF), could play an important role in the development and progression of cutaneous squamous cell carcinomas (SCC). PMID: 27019369
- Acetylation of lysine 109 modulates PXR DNA binding and transcriptional activity; PXR acetylation status and transcriptional activity are modulated by E1A binding protein (p300) and SIRT1. PMID: 26855179
- We show that a DUX4 minigene, bearing only the homeodomains and C-terminus, is transcriptionally functional and cytotoxic, and that overexpression of a nuclear targeted C-terminus impairs the ability of WT DUX4 to interact with p300 and to regulate target genes. PMID: 26951377
- These results suggest that OCT attenuates SGC-7901 cell proliferation by enhancing P300-HAT activity through the interaction of ZAC and P300, causing a reduction in pS10-H3 and an increase in acK14-H3. These findings provide insight for future research on OCT and further demonstrate the potential of OCT to be used as a therapeutic agent for gastric cancer PMID: 28260048
- High p300 expression is associated with migratory and invasive behavior in pancreatic cancer. PMID: 26695438
- Data show that HTLV-1 basic leucine zipper (bZIP) factor (HBZ) represses p53 activity by direct inhibition of the histone acetyltransferase (HAT) activity of p300/CBP and the HAT activity of HBO1: [HBZ] PMID: 26625199
- p300 protein and mRNA were not expressed in normal brain, but were expressed in pediatric astrocytoma in levels decreasing with tumor grade. PMID: 23407894
- By characterizing six novel EP300-mutated Rubinstein-Taybi patients patients, this study provides further insights into the EP300-specific clinical presentation and expands the mutational repertoire including the first case of a whole gene deletion. PMID: 26486927
- The axis EP300-->E-cadherin, which is controlled by the miR-106b~25 cluster, regulates paclitaxel resistance in breast cancer cells by apoptosis evasion independent of ABC transporters. PMID: 26573761
- RORgammat is acetylated, and this acetylation is reciprocally regulated by the histone acetyltransferase p300 and the histone deacetylase HDAC1. PMID: 26549310
- levels of p300 protein are temporally maintained in ligand-enhanced skeletal myocyte development. this maintenance of p300 protein is observed at the stage of myoblast differentiation, which coincides with an increase in Akt phosphorylation. PMID: 26354606
- PIAS1 enhances p300 recruitment to c-Myb-bound sites through interaction with both proteins. In addition, the E3 activity of PIAS1 enhances further its coactivation PMID: 27032383
- coactivator p300 mediates cytokine-induced hiNOS transactivation by forming a distant DNA loop between its enhancer and core promoter region PMID: 26751080
- BCL6 repression of EP300 in human diffuse large B cell lymphoma cells provides a basis for rational combinatorial therapy. PMID: 21041953
顯示更多
收起更多
-
相關疾病:Rubinstein-Taybi syndrome 2 (RSTS2)
-
亞細胞定位:Cytoplasm. Nucleus. Chromosome.
-
數據庫鏈接:
Most popular with customers
-
-
YWHAB Recombinant Monoclonal Antibody
Applications: ELISA, WB, IHC, IF, FC
Species Reactivity: Human, Mouse, Rat
-
Phospho-YAP1 (S127) Recombinant Monoclonal Antibody
Applications: ELISA, WB, IHC
Species Reactivity: Human
-
-
-
-
-